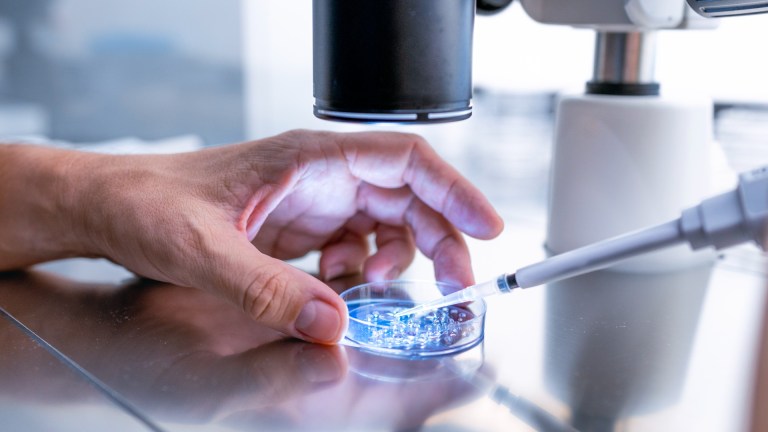
Alabama Clinics Halt IVF Services Following Court Ruling That Embryos Have Same Rights As Children

One of Alabama’s biggest hospitals has halted IVF services following the Alabama Supreme Court ruling that embryos have the same rights as children.
According to AP, the Alabama Supreme Court ruled last week that couples who were trying in vitro fertilization and lost frozen embryos in an accident at a south Alabama storage facility can sue under the state’s wrongful death law.
What Does The Ruling On Frozen Embryos Mean?
For context, the SC justices reversed a lower court ruling that dismissed the wrongful death claim on the grounds that the embryos were not a person or child.
The court had previously ruled that couples could sue when a pregnant woman lost a fetus. Last Friday (Feb. 16), the court said that “extrauterine children” were also covered under the wrongful death law.
“Unborn children are ‘children’ under the Act, without exception based on developmental stage, physical location, or any other ancillary characteristics,” Justice Jay Mitchell wrote in his opinion.
The court heavily relied on both the wording of the wrongful death statute and language added to the Alabama Constitution in 2018, stating that Alabama protects the “rights of the unborn child.”
To be clear, while the frozen embryos now have the same rights as children, it doesn’t guarantee personhood — at least not yet.
According to Mary Ziegler, the Martin Luther King Jr. Professor of Law at the University of California, the court left some leeway in their language.
“The court was pretty clear that they didn’t have to say whether the fetuses or embryos had constitutional rights. They were just saying that for the purposes of this wrongful death law they’re persons or children,” Mary said. “I think people in Alabama are rightly expecting that this is the tip of the iceberg though, and this ruling will lead to more down the road.”
Alabama Clinics Halt IVF Treatments
Since then, some of Alabama’s biggest IVF service providers, including the University of Alabama at Birmingham Hospital, have had no choice but to pump the brakes on their IVF procedures.
“We understand some patients wish to transport their embryos to another facility,” the hospital said in a statement on Friday (Feb. 23), per ABC News.
“Companies that transport embryos are also assessing the risks associated with the Alabama Supreme Court ruling, and we are working to identify a company that is able and willing as soon as possible. It is our goal to help patients who are interested in this option do so safely, but — at this time — there are no options available. We want to assure patients that embryos currently stored at UAB are safe here.”
The new ruling could potentially deem the process of IVF, which involves creating multiple embryos, as illegal. The hospital mentioned above is just one of many medical centers that must follow suit in Alabama, per the court ruling.
Mobile Infirmary, an affiliate of Infirmary Health, and Alabama Fertility Specialists have also announced their decision to halt IVF treatments, according to AL.
IVF treatments, which were once considered a beacon of hope for couples struggling with infertility, have now more or less become a source of legal worry and uncertainty.
Alabama woman who has spent $50,000 over two years on IVF treatment: I want to be a mom. We want to build a family and I think that should be our choice. This is an incredibly grueling experience. Our timeline is now in jeopardy. We are on an indefinite pause pic.twitter.com/nNx7jTD97Q
— Biden-Harris HQ (@BidenHQ) February 23, 2024
Social Media & Vice President Kamala Harris Reacts To Court’s Embryo Ruling
The thought of doctors and patients possibly facing criminal charges for partaking in IVF treatments has since led to a split debate among social media users on X.
Why Alabama’s ruling on IVF disproportionately harms Black women and gender-expansive people: a thread 🧵 ⬇️
— In Our Own Voice (@BlackWomensRJ) February 23, 2024
Imagine being a woman in Alabama who's voted GOP all her life, who can't give birth because of some medical condition, and now can't get the IVF treatment she needs because of that ridiculous AL Supreme Court ruling. The BBC interviewed such a person.
— Sean Black Lives Matter. I stand with Ukraine. (@SeanFlan45) February 24, 2024
One user by the name @NatalieWren15 seemed devastated by the news as she posted:
“Oh my god! My daughter was born with the help of us using an egg donor. I know the struggle. This makes ZERO medical sense and is surely designed to wipe out IVF. Looks like the IVF business is about to go broke in backward Alabama.”
Another X user named @DogsNDemocrats seemed just as upset in their weigh-in.
“First abortions, now Alabama is going after IVF treatments, in vitro fertilization, to help couples conceive. They want RIGHTS for fertilized, frozen embryos often discarded once one is implanted successfully.”
The ruling has also received criticism from related nonprofits and politicians, including the American Society for Reproductive Medicine and Vice President Kamala Harris.
The Alabama ruling is a devastating reminder that we must fight to keep family building a fundamental right. Urge your members of Congress to COSPONSOR the Access to Family Building Act to protect IVF and families across the country using our action alert: https://t.co/Ic89GG5W3b
— ASRM (@ASRM_org) February 23, 2024
Meanwhile, VP Harris wrote:
“This decision is outrageous − and it is already robbing women of the freedom to decide when and how to build a family,” Harris said in a tweet on Wednesday (Feb. 21).
This decision is outrageous—and it is already robbing women of the freedom to decide when and how to build a family. https://t.co/N04pReaM2B
— Kamala Harris (@KamalaHarris) February 21, 2024
First, extremists in Alabama told women they do not have a right to end a pregnancy.
Now, the Alabama Supreme Court's ruling puts their right to start a family at risk.
This decision is another reminder of what is at stake in our fight to protect reproductive freedom.
— Vice President Kamala Harris (@VP) February 23, 2024
RELATED: Georgia Department Of Revenue Announces That Residents Can Now Claim Embryos As Dependents On Their Taxes
Associated Press reporters Kim Chandler and Geoff Mulvihill contributed to this report.